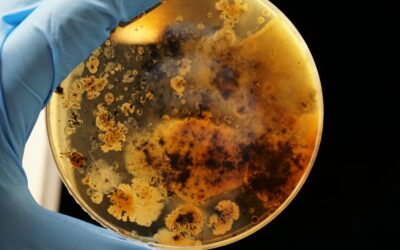

Our blogs
What the seasons can teach us about managing change
Just as the seasons have a predictable cycle, so there is a natural ebb and flow to business. The rhythm of your organisation may be linked to your...
A leader’s guide to dealing with problems
Dealing with problems is part of everyday life, but for leaders it’s a moment which can be of enormous importance to your leadership, your...
Why you should stop striving to be a success
As we have observed before, success means different things to different people, but the concept of trying to ‘be a success’ seems inherently...
Clarity: the secret of good teamwork
We have worked with thousands of teams over the years, all of them with their own unique characteristics and dynamics. But when we ask leaders to...
Why slowing down to speed up really works
The concept of slowing down to speed up is so counter intuitive that for years I remained unconvinced of its merit. Intellectually it appears to...
Making sense of being present
A couple of years ago I wrote a blog about how being present is the greatest gift you can give someone. At the time I was particularly focused on...
Finding balance in business and in life
“Life is like riding a bicycle. To keep your balance, you must keep moving” – Albert Einstein Finding balance in business and in life is a constant...
Saving our best for when?
I had the poignant task of clearing out my parents’ home a while ago. Amongst many memories unearthed, I came across the most special crystal...
Perform better, be happier: three simple steps to avoid dis-ease
Could it be true that the age-old maxim of ‘no pain, no gain’ is nonsense? What if the effortless path is the best one? It is increasingly clear...
Let’s start something new!
Get in touch with us today and take the first steps to transforming your business.